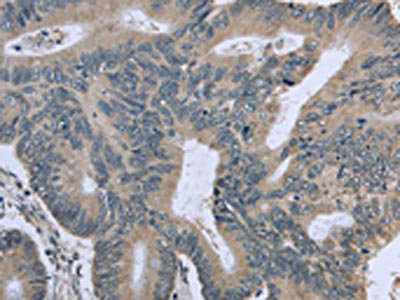

BMX Antibody
-
中文名稱:BMX兔多克隆抗體
-
貨號:CSB-PA979712
-
規(guī)格:¥1100
-
圖片:
-
The image on the left is immunohistochemistry of paraffin-embedded Human colon cancer tissue using CSB-PA979712(BMX Antibody) at dilution 1/30, on the right is treated with fusion protein. (Original magnification: ×200)
-
The image on the left is immunohistochemistry of paraffin-embedded Human cervical cancer tissue using CSB-PA979712(BMX Antibody) at dilution 1/30, on the right is treated with fusion protein. (Original magnification: ×200)
-
-
其他:
產(chǎn)品詳情
-
Uniprot No.:
-
基因名:
-
別名:Bmx antibody; BMX non receptor tyrosine kinase antibody; BMX_HUMAN antibody; BONE MARROW KINASE; X-LINKED antibody; Bone marrow tyrosine kinase gene in chromosome X protein antibody; Cytoplasmic tyrosine protein kinase BMX antibody; Cytoplasmic tyrosine-protein kinase BMX antibody; Epithelial and endothelial tyrosine kinase antibody; ETK antibody; NKT38 antibody; NTK 38 antibody; NTK38 antibody; Protein tyrosine kinase BMX antibody; PSCTK 2 antibody; PSCTK 3 antibody; PSCTK2 antibody; PSCTK3 antibody
-
宿主:Rabbit
-
反應(yīng)種屬:Human,Mouse
-
免疫原:Fusion protein of Human BMX
-
免疫原種屬:Homo sapiens (Human)
-
標(biāo)記方式:Non-conjugated
-
抗體亞型:IgG
-
純化方式:Antigen affinity purification
-
濃度:It differs from different batches. Please contact us to confirm it.
-
保存緩沖液:-20°C, pH7.4 PBS, 0.05% NaN3, 40% Glycerol
-
產(chǎn)品提供形式:Liquid
-
應(yīng)用范圍:ELISA,IHC
-
推薦稀釋比:
Application Recommended Dilution ELISA 1:2000-1:5000 IHC 1:50-1:200 -
Protocols:
-
儲存條件:Upon receipt, store at -20°C or -80°C. Avoid repeated freeze.
-
貨期:Basically, we can dispatch the products out in 1-3 working days after receiving your orders. Delivery time maybe differs from different purchasing way or location, please kindly consult your local distributors for specific delivery time.
-
用途:For Research Use Only. Not for use in diagnostic or therapeutic procedures.
相關(guān)產(chǎn)品
靶點詳情
-
功能:Non-receptor tyrosine kinase that plays central but diverse modulatory roles in various signaling processes involved in the regulation of actin reorganization, cell migration, cell proliferation and survival, cell adhesion, and apoptosis. Participates in signal transduction stimulated by growth factor receptors, cytokine receptors, G-protein coupled receptors, antigen receptors and integrins. Induces tyrosine phosphorylation of BCAR1 in response to integrin regulation. Activation of BMX by integrins is mediated by PTK2/FAK1, a key mediator of integrin signaling events leading to the regulation of actin cytoskeleton and cell motility. Plays a critical role in TNF-induced angiogenesis, and implicated in the signaling of TEK and FLT1 receptors, 2 important receptor families essential for angiogenesis. Required for the phosphorylation and activation of STAT3, a transcription factor involved in cell differentiation. Also involved in interleukin-6 (IL6) induced differentiation. Plays also a role in programming adaptive cytoprotection against extracellular stress in different cell systems, salivary epithelial cells, brain endothelial cells, and dermal fibroblasts. May be involved in regulation of endocytosis through its interaction with an endosomal protein RUFY1. May also play a role in the growth and differentiation of hematopoietic cells; as well as in signal transduction in endocardial and arterial endothelial cells.
-
基因功能參考文獻(xiàn):
- These results suggested that BMX can promote cell proliferation through PI3K/AKT/mTOR and STAT3 signaling pathways in cervical cancer cells. PMID: 28514765
- The studies suggested that BMXDeltaN might play roles in lung tumorigenicity, with expression of BMXDeltaN promoting cell growth, cell migration, and cell transformation. PMID: 28422715
- results demonstrate that cleaved BMX is a novel N-end rule substrate, and its degradation exhibits a novel interplay between substrate phosphorylation and N-end rule degradation, revealing an increasing complex regulatory network of apoptotic proteolytic signaling cascades. PMID: 27601470
- Data indicate that EPHA3 is involved in regulating the multidrug resistance (MDR) of small cell lung cancer (SCLC) via PI3K/BMX/STAT3 signaling and may be a therapeutic target in SCLC. PMID: 27101199
- Report BMX-ARHGAP gene fusion in gastric cardia adenocarcinoma. PMID: 25499959
- These findings suggested that polymorphisms of the BMX gene could be a potential predictor of clinical symptoms following mTBI. PMID: 24860816
- BMX is an antiapoptotic downstream effector of PI3K, independent of AKT. PMID: 24709422
- The effects of dietary K(+) on Bmx were more pronounced PMID: 24785188
- Overexpression of ETK is associated with the malignancy and disease progression of renal cell carcinoma. PMID: 24606948
- This review characterizes the role of BMX in inflamamtion, cardiovascular disease and cancer. PMID: 22449076
- Etk/BMX may play a role in protection of NPC cells from apoptosis. PMID: 21339702
- study concludes that BMX is an essential component of inflammatory cytokine signaling and that catalytic, as well as noncatalytic functions of BMX are involved PMID: 21471444
- Deregulation of ETK may attribute to the elevated activity of STAT3 and AKT frequently detected in bladder cancer. PMID: 21408190
- BMX is associated with multi-drug resistance of K562/HHT cell line. PMID: 19951526
- Constitutively active STAT3 rescued the effects of BMX downregulation, supporting that BMX signals through STAT3 in glioblastoma stem cells (GSCs). PMID: 21481791
- possible role in regulation of vesicle trafficking PMID: 11877430
- Investigate Bmx mediates VEGF-dependent lymphangiogenic signaling. PMID: 20864667
- by preventing binding of Etk/Bmx to PAR(1) -C-tail, hPar1 oncogenic properties are abrogated PMID: 20559570
- high expression of Etk occurs in 74.6% of SCLC cases, but only in 40% of NSCLC cases, and there is marked difference in the expression levels of Bcl-2, Bcl-X(L) and p53 between Etk-positive and Etk-negative SCLC cases PMID: 20206622
- BMX/Etk is a TNFR2-specific kinase involved in TNF-induced angiogenic events PMID: 12370298
- Etk activation is essential for transducing the EGF-induced apoptotic signaling in breast cancer cells. PMID: 14676838
- Pim1 and Etk are required for IL6-induced activation of androgen receptor-mediated transcription in prostate cancer. PMID: 14981536
- Bmx is a downstream Rap1 effector in VEGF-induced endothelial cell activation. PMID: 15207703
- two isoforms of Pim-1 kinase may regulate distinct substrates and the 44 kDa Pim-1 may play a more prominent role in drug resistance in prostate cancer cells and interact directly with tyrosine kinase Etk/BMX PMID: 16186805
- Etk transgenic mouse model may be a useful tool for studying the functions of Etk and identification of new molecular markers and drug targets relevant to human diseases. PMID: 16912182
- Role of Bmx in ischemia-mediated arteriogenesis/angiogenesis: response to ischemia, enhanced in transgenic mice. PMID: 16932810
- results demonstrate that Bmx is a critical downstream target of the constitutively active PI 3-kinase in PTEN-deficient PCa cells and further show that Bmx is recruited by the EGF receptor and ErbB3 and activated in response to their respective ligands PMID: 17823122
- Mechanisms regulating IL-6 production led to the discovery that the Tec kinase bone marrow tyrosine kinase gene in chromosome X (Bmx) regulates Toll-like receptor 4-induced IL-6 production. PMID: 18025155
- Etk/Bmx may have different biological roles in tumor and nontumor cells, and may be involved in regulating hepatocyte differentiation by c-Fos activation in HCC. PMID: 18196928
- In fibroblast-like synoviocytes of rheumatoid arthritis patients, Etk is implicated in the cross-talk between focal adhesion kinase (FAK) and myeloid differentiation factor 88 (MyD88) pathways. PMID: 18292575
- Bmx kinase activity in fibroblasts from rheumatoid synovium is increased following LPS stimulation; Bmx is involved in the regulation of LPS-induced IL-6 and VEGF production via mRNA stabilisation. PMID: 18402776
- Pretreatment of umbilical vein cells with a pharmacologic inhibitor of Bmx, LFM-A13, produced significant radiosensitization of endothelial cells measured by clonogenic survival analysis and apoptosis. PMID: 18413754
顯示更多
收起更多
-
亞細(xì)胞定位:Cytoplasm. Note=Localizes to the edges of spreading cells when complexed with BCAR1.
-
蛋白家族:Protein kinase superfamily, Tyr protein kinase family, TEC subfamily
-
組織特異性:Highly expressed in cells with great migratory potential, including endothelial cells and metastatic carcinoma cell lines.
-
數(shù)據(jù)庫鏈接:
Most popular with customers
-
-
YWHAB Recombinant Monoclonal Antibody
Applications: ELISA, WB, IHC, IF, FC
Species Reactivity: Human, Mouse, Rat
-
Phospho-YAP1 (S127) Recombinant Monoclonal Antibody
Applications: ELISA, WB, IHC
Species Reactivity: Human
-
-
-
-
-